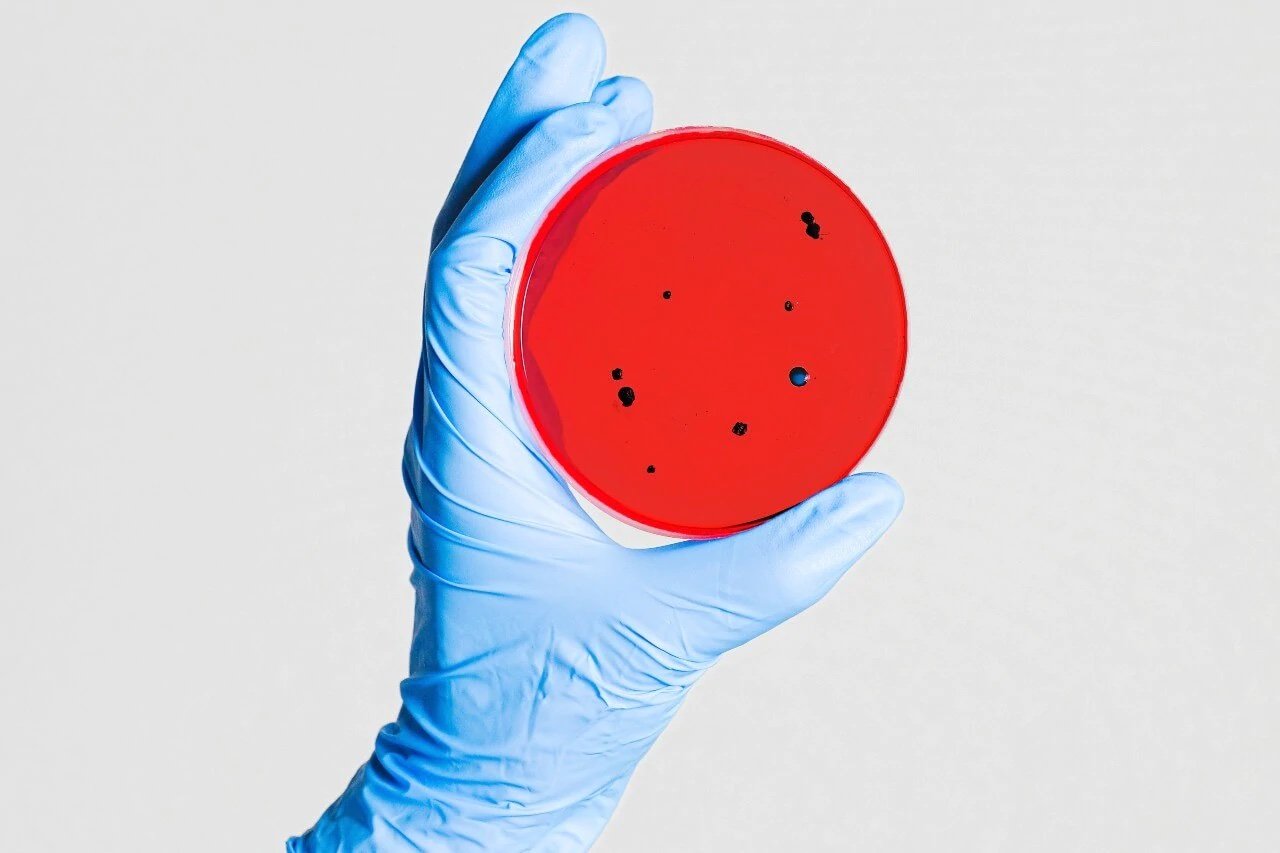
Five Stars For Topical Probiotics

This is a difficult story to write. Not because I have any kind of fear of headlice but because from the moment of my first keystroke my scalp began to crawl and itch. That’s the power of nits. The mere mention of these creepy creatures can elicit a physical response identical to an infestation of one thousand parasites crawling, spitting and breeding upon a scalp.
I know I am not alone. Psychosomatic itching is a “genuine physical affliction caused by emotional anxiety,” says San Francisco-based psychologist Juli Fraga. Tell me about it.
I have a theory about this – that the trauma visited upon us as children is to blame. The hours of painful nit combing, the sting of insecticide shampoo and the shame of being “that kid”, the encompassing fear of being singled out in the classroom or worse – on the playground.
Is this fear nature’s way of creating a massive cohort of people who are consumed with paranoia and thereby stop a community infestation in its tracks? Humans are outnumbered by insects at a rate of 200 million to one and I’m sure it’s no coincidence that bugs are a regular feature in horror films. The fear goes deep.
Apart from social ostracization there is not much to fear from headlice. They don’t carry or spread disease. Headlice are mainly transferred by direct head to head contact - crawling from one head to another when heads are touching. They have a bad reputation for circulating in schools but it’s much more likely that they are picked up at home and on playdates or sleepovers than in the classroom.
FAKE NEWS
There are endless myths regarding headlice, here are a few that can be ignored:
X Lice can jump, fly or swim - Crawling only for these critters
X Poor people get lice – Lice don’t care about your bank account
X Pet animals can carry lice – Lice can’t survive on animals
X Lice prefer dirty hair – All a louse needs to make its home is a warm human
X Lice prefer long hair – see above
X Lice breed in bedding – Nits require the warmth of human skin to survive
DEAL WITH IT
There is no sure-fire way to prevent head lice other than avoiding human contact and not wearing other people's hats.
MANUAL
Doing it the old-fashioned way is a bit of a chore but one of the most effective methods. Saturate the hair with water either in the shower or with a water spray bottle. Water slows down the lice making them easier to catch in the comb. Beginning at the nape take down a fine section of hair and comb it through from the scalp to the ends with a fine nit comb. You should see eggs and lice collect in the teeth of the comb, wipe them off onto a tissue. Repeat with fine sections working your way to the top of the head until all the hair has been combed. Burn the tissue in the fires of hell just to be sure.
CHEMICAL FREE 4% Dimethicone liquid gel
Dimethicone is a form of silicon derived from sand. It works in treating lice by suffocation, targeting the breathing holes of headlice, eggs and larvae, depriving them of oxygen impairing their ability to regulate water. Dimethicone treatments don’t contain pesticides, insecticides, or neurotoxins. Dimethicone liquid gel can be obtained by prescription from your doctor, and it’s free. Use this lotion to saturate the hair and scalp and comb through to ensure every strand is covered. Wait 8 hours then shampoo the lotion from the hair. Repeat this treatment every 7 days until lice and nit free.
ELECTRIFIED
Headlice combs are essentially bug zappers, emitting a small electrical charge that is not sensed by humans but is lethal to lice and eggs. Some even incorporate a vacuum function to collect the tiny corpses for you. This is performed on dry hair, again in methodical small sections to ensure coverage of the entire head and hair. A satisfying method but no more effective than a regular nit comb.
MEDICATED
Treatments that you can pick up from your local chemist are less popular now as their effectiveness doesn’t really compete with non-chemical treatments and active ingredients may cause skin irritation and potentially cause more harm than the lice would. Usually, these come in shampoo form and contain one or more active ingredients for killing lice and eggs. It’s important to follow the manufacturer’s instructions to ensure the effectiveness of these treatments.
PYRETHRINS
These are naturally occurring botanical insecticides extracted from the chrysanthemum flower. This ingredient can only kill live lice, not unhatched eggs. A second treatment is recommended 9 to 10 days after the first treatment to kill any newly hatched lice before they can produce new eggs.
PERMETHRIN
A synthetic pyrethroid is similar to naturally occurring pyrethrins. Permethrin may continue to kill newly hatched lice for several days after treatment. A second treatment is necessary on days 7-10 to kill any newly hatched lice before they can produce new eggs. The use of permethrin as a topical treatment or shampoo for head lice or scabies is associated with a relatively low risk of toxicity if used according to directions.
MALATHION or DERBAC M
Prescription only. Malathion is an organophosphate. It works by paralyzing and killing lice and their eggs. In high doses Organophosphates are highly toxic and may be absorbed through the skin - In very low concentrations some less toxic organophosphates have been used in head lice products for human use.
HOME REMEDIES
HEAD SHAVE
Like using a sledgehammer to crack a nut. - Do not recommend
PLANT OILS
A similar method to Dimethicone gel, in theory suffocating the lice. Tea Tree oil and Lavender Oil have the best success rate with lice although unlikely to kill the nits (eggs) - Recommend as a regular weekly treatment.
MAYONNAISE
There is no proof that this works other than a few anecdotes, it does contain Biotin though which is great for hair health. – Probably not.
STRAIGHTENING IRON
An unsafe and ineffective method as it does not kill lice or eggs near the scalp and can cause serious burns. - Absolutely not!
VASELINE/PETROLEUM JELLY
The suffocation method again. Seems like this would be very difficult to get out of your hair following treatment. – There are better options.
KEROSENE/FLYSPRAY/SPOT-ON
Never Ever Ever.
- 4% dimethicone lotion – a subsidised treatment for head lice BPAC, NZ, 2017
- https://bpac.org.nz/bpj/2013/december/docs/BPJ57-pyrethroid.pdf
- https://www.ncbi.nlm.nih.gov/pmc/articles/PMC3038924/
- https://www.cdc.gov/parasites/lice/head/gen_info/faqs_malathion.htmlhttps://www.healthnavigator.org.nz/health-a-z/h/head-lice/
- https://www.webmd.com/skin-problems-and-treatments/how-to-choose-use-lice-combs